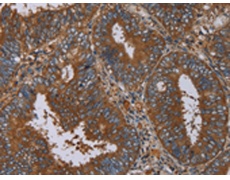
一抗

英文名稱: Anti-IL27RA rabbit polyclonal antibody
別 名: CRL1; TCCR; WSX1; IL27R; IL-27RA; zcytor1
儲(chǔ) 存: 冷凍(-20℃)
標(biāo) 記 物: Unconjugate
克隆類(lèi)型: rabbit polyclonal
技術(shù)規(guī)格
|
Background: |
In mice, CD4+ helper T-cells differentiate into type 1 (Th1) cells, which are critical for cell-mediated immunity, predominantly under the influence of IL12. Also, IL4 influences their differentiation into type 2 (Th2) cells, which are critical for most antibody responses. Mice deficient in these cytokines, their receptors, or associated transcription factors have impaired, but are not absent of, Th1 or Th2 immune responses. This gene encodes a protein which is similar to the mouse T-cell cytokine receptor Tccr at the amino acid level, and is predicted to be a glycosylated transmembrane protein. |
|
Applications: |
ELISA, WB, IHC |
|
Name of antibody: |
IL27RA |
|
Immunogen: |
Fusion protein of human IL27RA |
|
Full name: |
interleukin 27 receptor, alpha |
|
Synonyms: |
CRL1; TCCR; WSX1; IL27R; IL-27RA; zcytor1 |
|
SwissProt: |
Q6UWB1 |
|
ELISA Recommended dilution: |
2000-5000 |
|
IHC positive control: |
Human colon cancer and human brain |
|
IHC Recommend dilution: |
50-200 |
|
WB Predicted band size: |
69 kDa |
|
WB Positive control: |
Mouse thymus and heart tissue |
|
WB Recommended dilution: |
200-1000 |


 購(gòu)物車(chē)
購(gòu)物車(chē) 幫助
幫助
 021-54845833/15800441009
021-54845833/15800441009